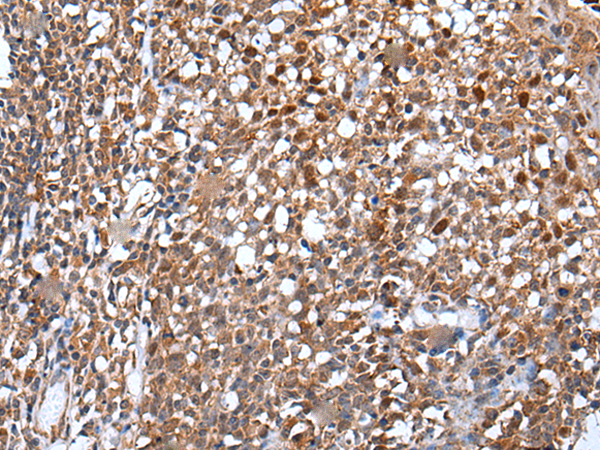

|
Background: |
The protein encoded by this gene contains multiple N-terminal WD40 domains and a C-terminal high mobility group (HMG) box. WD40 domains are found in a variety of eukaryotic proteins and may function as adaptor/regulatory modules in signal transduction, pre-mRNA processing and cytoskeleton assembly. HMG boxes are found in many eukaryotic proteins involved in chromatin assembly, transcription and replication. Alternative splicing results in two transcript variants encoding different isoforms. |
|
Applications: |
ELISA, IHC |
|
Name of antibody: |
WDHD1 |
|
Immunogen: |
Synthetic peptide of human WDHD1 |
|
Full name: |
WD repeat and HMG-box DNA binding protein 1 |
|
Synonyms: |
AND1; CTF4; AND-1; CHTF4 |
|
SwissProt: |
O75717 |
|
ELISA Recommended dilution: |
5000-10000 |
|
IHC positive control: |
Human esophagus cancer |
|
IHC Recommend dilution: |
25-100 |

購物車
購物車 幫助
幫助
 021-54845833/15800441009
021-54845833/15800441009
